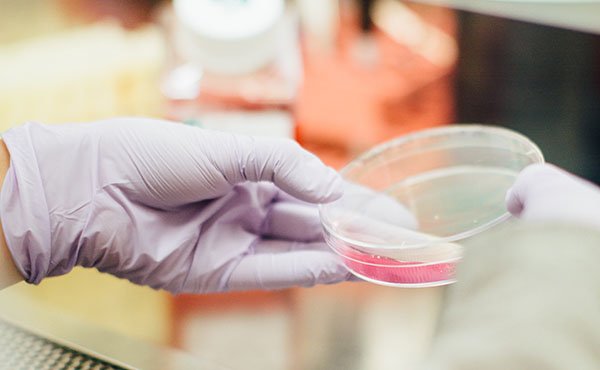

Mi mujer llevaba varios meses sufriendo un extremo cansancio, que le hizo visitar médicos de diferentes especialidades, sin que encontrase el motivo del mismo. Por fin, por indicación de uno que se fijó en un recuento globular anormal, visitó a un hematólogo, que pidió análisis complejos y, al cabo de un mes, detectaron el síndrome de Filadelfia, es decir, una leucemia mieloide crónica.
No había antecedentes en la familia, ni sabíamos lo que era, pero mi mujer lo presentía y para ella no fue una sorpresa, pero sí un momento duro, para ella y para toda la familia. La doctora dijo que antes de hacer una extracción de médula ósea, para valorar con precisión la medicación necesaria, quería repetir el análisis para estar segura, aunque los falsos positivos eran improbables.
la doctora nos dijo, que no la iba a medicar porque no habían aparecido células cancerosas en la muestra de MÉDULA ósea
Desde aquel día, por recomendación de un amigo, inicié la novena a Montse Grases, y la novena se convirtió en una oración diaria durante muchas semanas, porque al cabo de otro mes, el nuevo análisis confirmó exactamente el primero, y luego, tras hacer la biopsia de médula, también tardaron tiempo en llamarnos para consulta.
Me dio un vuelco el corazón, al pensar que la enfermedad había pasado de crónica a aguda y ya no había nada que hacer
Aquel día, llegamos acompañados de dos hijas para ver la medicación prescrita y vimos algo alterada a la doctora, que con circunloquios nos terminó diciendo que no iba a dictar medicación. Me dio un vuelco el corazón, al pensar que la enfermedad había pasado de crónica a aguda y ya no había nada que hacer, pero la doctora nos dijo, que no la iba a medicar porque no habían aparecido células cancerosas en la muestra de médula ósea, lo que incluso había verificado con otros especialistas.
El recuento globular anormal persistía pero que con hacer controles normales de seguimiento bastaba, y que la leucemia quedaba descartada. Convencido de que ha sido una gracia recibida de Dios por mediación de Montse, comunico este favor, y sigo rezando la oración para la devoción privada en acción de gracias.
G. T. - España
►Clic aquí para enviar el relato de un favor recibido.
También puede comunicar la gracia que se le ha concedido mediante correo postal a la Oficina de las causas de los santos de la prelatura del Opus Dei (Calle Diego de León, 14, 28006 Madrid, España) o a través del correo electrónico ocs.es@opusdei.org.
►Clic aquí para hacer un donativo.
También puede enviar una aportación por transferencia a la cuenta bancaria de la Asociación de Cooperadores del Opus Dei con IBAN número ES53 2100 1547 7502 0024 4065 y BIC, CAIXESBBXXX en La Caixa (agencia urbana de la calle Cartagena, 4, 28028 Madrid, España).